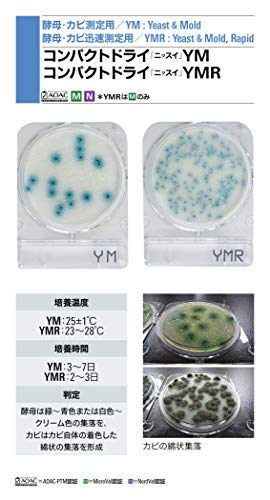
main

販売情報
画面をスクロールすると販売情報が更新されます。
最終更新:
最安値ショップ
最安値ショッピングサイト
実質価格ランキング
商品情報

培地調製のいらない菌数測定用の培地です。 用途:酵母・カビ測定用 入数:1箱(4枚/袋×60袋入) 保存方法:1~30℃(室温) 使用期限:製造より18ヶ月 製品箱サイズ:26cm*30cm*25cm 重量:2800g ※事業者向け商品です。ご使用後の培地類は、速やかにオートクレーブ滅菌後、地方自治体または国の法規に準拠し、安全に処分してください。
| JANコード | 4987302067473 |
|---|---|
| 型番 | 2-9024-06 |
| メーカー | 日水製薬 |
| ブランド | 日水製薬 |











![[2024 New Release] Tabletop Humidifier, Small, Type-C Rechargeable, Tabletop Humidifier, Disinfectant, Large Capacity, 11.8 f](https://images-fe.ssl-images-amazon.com/images/I/41hsGJiWNfL._AC_UL600_SR600,400_.jpg)


